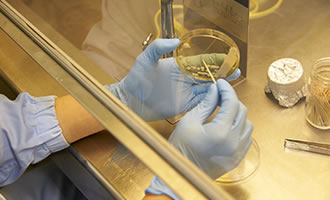

生産工場での取り組み
製造工程管理
生産設備の管理
各工程で、目視による状態確認及び各種測定機器により、設計した工程からの逸脱が無いことを確認し、安全安心な製品作りに取り組んでいます。
- 原料仕込み
- 加工
抽出、焙煎、調合、乾燥他 - 異物確認
各種フィルター、マグネット、X線
金属検出器等 - 充填・包装
- 製品


製品検査
専門スタッフによる分析を行い、常に安全安心な製品を皆様にお届けしております。
- ① 官能検査
- ② 理化学分析
- ③ 細菌検査


各工程で、目視による状態確認及び各種測定機器により、設計した工程からの逸脱が無いことを確認し、安全安心な製品作りに取り組んでいます。


専門スタッフによる分析を行い、常に安全安心な製品を皆様にお届けしております。